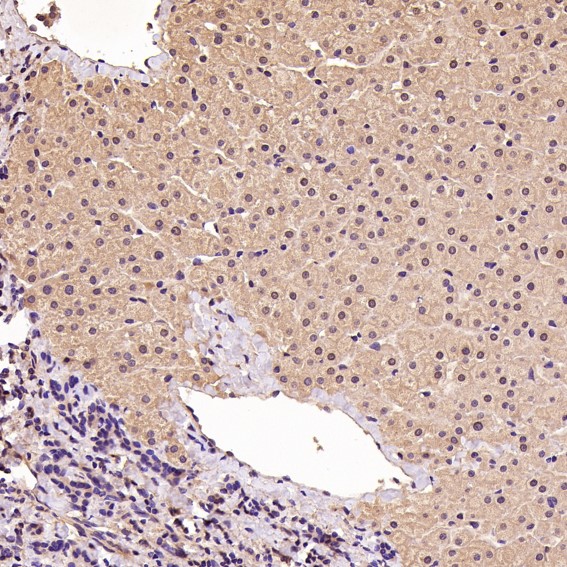
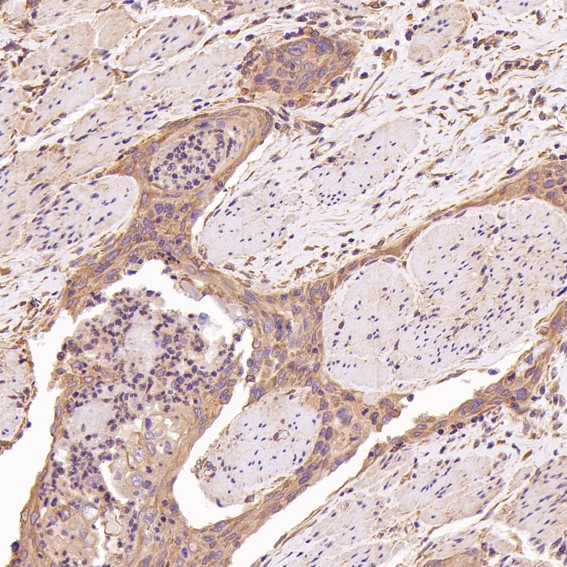
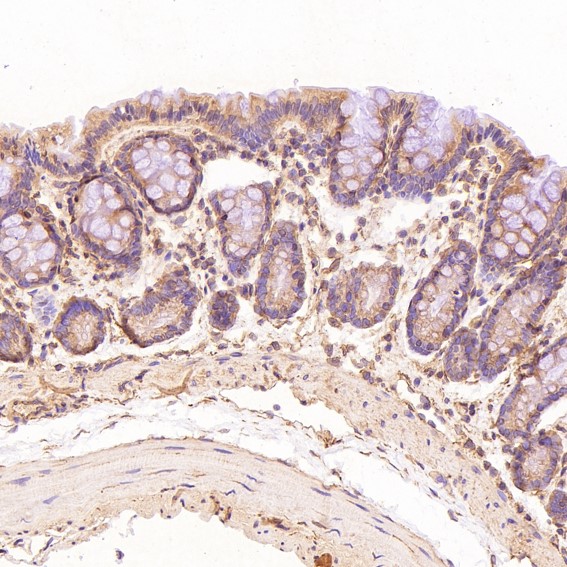

单克隆抗体
Cyclin D1 Antibody (CY5404)
References (14)
UniProt:P24385
Application:WB,IHC,ICC/IF,IP
Reactivity:Human,Mouse,Rat
Source:Rabbit mAb
Cyclin D1 Antibody (CY5404)
UniProt:P24385
Application:WB,IHC,ICC/IF,IP
Reactivity:Human,Mouse,Rat
Source:Rabbit mAb
References(14)
http://www.abways.cn/showproduct.asp?cid=CY5404
Tubulin gamma Antibody (CY5405)
UniProt:P23258
Application:WB,IHC,ICC/IF,IP,FC
Reactivity:Human,Mouse,Rat,Monkey,Chicken,Hamster,Cow,Dog,Fish,Xenopus,tropicalis
Source:Rabbit mAb
Tubulin gamma Antibody (CY5405)
UniProt:P23258
Application:WB,IHC,ICC/IF,IP,FC
Reactivity:Human,Mouse,Rat,Monkey,Chicken,Hamster,Cow,Dog,Fish,Xenopus,tropicalis
Source:Rabbit mAb
http://www.abways.cn/showproduct.asp?cid=CY5405
PSD95 Antibody (CY5407)
References (1)
UniProt:P78352
Application:WB,IHC,ICC/IF,IP,FC
Reactivity:Human,Mouse,Rat
Source:Rabbit mAb
PSD95 Antibody (CY5407)
UniProt:P78352
Application:WB,IHC,ICC/IF,IP,FC
Reactivity:Human,Mouse,Rat
Source:Rabbit mAb
References(1)
http://www.abways.cn/showproduct.asp?cid=CY5407
PBR Antibody (CY5408)
UniProt:P30536
Application:WB,IHC,ICC/IF,IP,FC
Reactivity:Human,Mouse
Source:Rabbit mAb
PBR Antibody (CY5408)
UniProt:P30536
Application:WB,IHC,ICC/IF,IP,FC
Reactivity:Human,Mouse
Source:Rabbit mAb
http://www.abways.cn/showproduct.asp?cid=CY5408
CDK5 Antibody (CY5409)
UniProt:Q00535
Application:WB,IHC,IP,FC
Reactivity:Human,Mouse,Rat
Source:Rabbit mAb
CDK5 Antibody (CY5409)
UniProt:Q00535
Application:WB,IHC,IP,FC
Reactivity:Human,Mouse,Rat
Source:Rabbit mAb
http://www.abways.cn/showproduct.asp?cid=CY5409

销售咨询
销售咨询 一键电话
一键电话